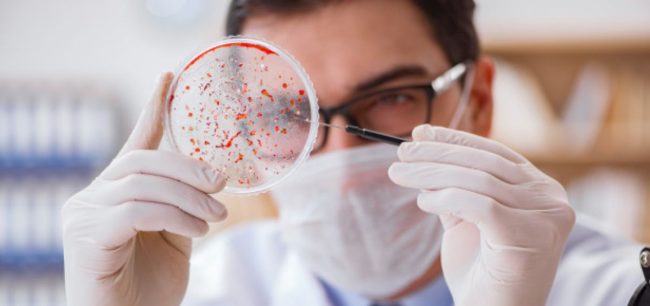
investigar

La atención temprana debería ser un derecho universal, indispensable para el tratamiento de enfermedades rara
Se habla de enfermedades raras (ER) en Europa cuando afectan a menos de 5 de cada 10 000 personas. Se calcula que existen de 6 000 a 7 000 enfermedades raras diferentes. Y aunque individualmente son poco frecuentes, en su conjunto constituyen un importante problema de salud pública: solo en España existen unos 3 millones…